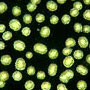

| Diese Seite dient als grobe Orientierungshilfe bezüglich der Vielfalt der bisher dokumentierten Formen und Arten. Ein Klick auf die Bilder führt dann zu den entsprechenden Großgruppen. Obgleich aus heutiger Sicht fragwürdig, richtet sich die Taxonomie dabei weitgehend nach der Einteilung von STREBLE/KRAUTER: "Das Leben im Wassertropfen". Obgleich aus taxonomischer und systematischer Sicht ebenfalls nicht korrekt, sind hier ebenfalls die "Blaualgen" (Cyanobacteria) mit aufgenommen . Zusätzlich wird noch weitere Literatur benutzt. |